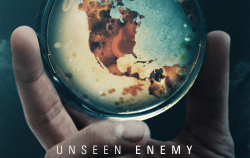

This week’s Pandora Report covers the passing of Graham Pearson, the winners of the 2023 Arms Control Person(s) of the Year contest, growing global COVID-19 case counts, the launch of ERINHA’s INTERCEPTOR project, and more.
Graham Pearson Dead at 88
Famed British scientist, civil servant, and author of The UNSCOM Saga: Chemical and Biological Weapons Non-Proliferation, Graham Pearson, died this month at the age of 88.
An obituary written by his cousin, Oliver Pickering, explains “Arising from a growing interest in arms control, which led him while still in post to work on verification methods to enforce the Biological Weapons Convention, in 1996 he joined Bradford University’s Department of Peace Studies as an honorary visiting research fellow in international security. His skills as an organiser, analyser and writer, helped by his boundless energy and genial personality, involved him in numerous meetings designed to strengthen the BWC, including in Geneva during Pugwash conferences on science and world affairs. He published widely in the field of chemical and biological weapons. Subsequently a visiting professor, he was made a DUniv of Bradford in 2018.”
Read more here.
2023 Arms Control Person(s) of the Year Winner Announced
The Arms Control Association announced the winners of its annual Arms Control Person of the Year contest. This year’s winners are the workers and technicians at the US Army Pueblo Chemical Depot in Colorado and the Blue Grass Army Depot in Kentucky. According to the Association’s press release, “The workers and technicians at the two chemical stockpile depots were nominated for their successful and safe completion of eliminating the last vestiges of the United States’ once-enormous declared stockpile of lethal chemical munitions as required by the 1997 Chemical Weapons Convention…Under the supervision of the U.S. Army’s Office of Assembled Chemical Weapons Alternatives, the last mustard gas munition was destroyed in June at Pueblo; Blue Grass destroyed the last missile loaded with Sarin nerve agent in July. The elimination program cost an estimated $13.5 billion.”
Read more here.
WHO Director-General Says Holiday Gatherings and JN.1 Variants Responsible for Increcased COVID-19 Cases Globally
WHO Director-General Tedros Adhanom Ghebreyesus told reporters Wednesday that a combination of holiday gatherings and the global spread of the JN.1 variant led to increased transmission of COVID-19 last month. Ghebreyesus said in a statement from Geneva, “Although 10,000 deaths a month is far less than the peak of the pandemic, this level of preventable deaths is not acceptable.”
The Director-General further added that it is “certain” cases are on the rise in places that have failed to report cases in a call to governments to increase surveillance and provide access to treatments and vaccines. The US CDC now estimates that the JN.1 variant is responsible for over 44% of COVID-19 cases nationally.
VOA explained in their article on the topic that, “Maria Van Kerkhove, technical lead at WHO for COVID-19, cited an increase in respiratory diseases across the globe due to the coronavirus but also flu, rhinovirus and pneumonia. “We expect those trends to continue into January through the winter months in the northern hemisphere,” she said, while noting increases in COVID-19 in the southern hemisphere — where it’s now summer…While bouts of coughs, sniffling, fever and fatigue in the winter are nothing new, Van Kerkhove said this year in particular, “We are seeing co-circulation of many different types of pathogens.”‘
European Research Infrastructure on Highly Pathogenic Agents Announces INTERCEPTOR Project
ERINHA recently announced the launch of its INTERCEPTOR project in a statement explaining, “INTERCEPTOR, short for INTERnational Cooperation of high containment research infrastructures: from Epidemic Preparedness TO Response, is a groundbreaking initiative led by the European Research Infrastructure on Highly pathogenic Agents (ERINHA) in collaboration with key high containment laboratories (HCLs) from Europe and around the world.”
“Emerging infectious diseases (EIDs) pose a global catastrophic risk, transcending borders and threatening humanity, akin to climate change and biodiversity loss. The recent COVID-19 pandemic underscored the critical importance of global cooperation, research coordination, and the sharing of data and expertise in effectively preparing for and responding to EIDs. Despite these lessons, significant challenges persist, hindering seamless cooperation among HCLs.”
“ERINHA, in partnership with other leading institutions, has taken a bold step to address these challenges by initiating the INTERCEPTOR project. The project’s consortium aims to establish and strengthen interactions with HCL research infrastructures worldwide, with a primary focus on enhancing pandemic preparedness and response capacities.”
DTRA, US Army Developing Treatment to Combat BW Threat Posed by Tularemia and Other Bacterial Agents
Researchers with the Defense Threat Reduction Agency, the United States Army Medical Research Institute of Infectious Diseases, and Walter Reed Army Institue of Research are working together to develop new antibiotics to treat tularemia as well as anthrax, plague, glanders, and melioidosis. “The partnered institutions seek to address increasing antibiotic resistance among these common bacteria, aiming to counteract the threat of antibiotic-resistant pathogens, both naturally occurring and those possibly engineered for malicious purposes,” according to Army Technology.
Read more about this collaboration and the history of tularemia as a biological agent in this piece by Andrew Salerno-Garthwaite.

“Fifty-Five Hours of Risk: The Dangerous Implications of Slow Attack Attribution”
Schar School adjunct professor JD Maddox recently published this article with West Point’s Modern War Institute in which he discusses the delayed attribution of the Islamic State’s dual suicide bombings in Kerman, Iran, earlier this month. He writes in part, “While the United States was not the target of the Islamic State’s physical attacks in Kerman, it was a target of intentional information releases, and the United States’ narrative vulnerability was on full display. Immediately after the attacks, a notorious US-based social media account claiming expertise in open-source intelligence alleged that the supreme leader of Iran ordered the Iranian military to stand down, and the posting attracted nearly seven hundred thousand views by the end of the first day, with thousands of likes and reposts—demonstrating the uncritical acceptance of unchecked information. Meanwhile, anti-Israel accounts on social media were quick to conflate Israel’s actions against Hamas with Israel’s purported attacks in Kerman, and the posts remained online even after Islamic State attribution. Furthermore, op-eds by activist anti-Israel publications like Tasnim News and the Tehran Times appeared after the attack, blaming Israel and the United States for the bombings. Posts like these are the kernels of misinformation from which deliberate disinformation campaigns can be grown.”
“The Evolving Landscape of U.S. Economic Security: The Confluence of Trade, Technology, and National Security”
Schar School adjunct professor Andrea Viski recently published this article in the Korea Economic Institutes journal, Korea Policy: “This paper examines the current evolution of U.S. economic security discourse to demonstrate the implications, challenges, and shortcomings of U.S. economic security tools and the catalyzing impact of technology. While component economic security considerations are broad and encompass issues from natural disaster planning to cybersecurity, this paper focuses specifically on the impact of trade and technology in the economic security context. It discusses the main influences and features of U.S. economic security policy as it relates to trade, technology, and the security of the supply chain. The paper includes sections on evolving notions of the dual-use concept; the need to manage and respond to technology flows with more effective strategies, and new foreign policy efforts and tools to strengthen economic security. The paper focuses on the trends forging the path for the United States to define economic security so closely with national security, and in exploring these trends, it delineates how the United States has implemented policies and adopted, reoriented, or created new policy tools designed to strengthen economic security. The paper also explores why the rapid evolution of emerging technologies has played such a defining role. Finally, the paper examines the effectiveness of the U.S. approach to economic security and its challenges and offers insights into how it can be strengthened in the future”
“ASPR Looks Back at 2023”
Dawn O’Connell, Assistant Secretary for Preparedness and Response, reflects on the last year at her agency in this piece, writing in part “We don’t have quiet, slow years at ASPR. We have years that require us to move quickly, to innovate often, and to get the most out of our teams and resources. 2023 was no exception. Looking back, I want us to remember the great work we did on behalf of the American people as we helped our country prepare for, respond to, and recover from public health emergencies and disasters. In 2023, great work happened throughout ASPR, here are some highlights…”
“National Security Commission on Emerging Biotechnology Interim Report”
The National Security Commission on Emerging Biotechnology (NCSEB) recently released an interim report following its first year of work. The report’s executive summary explains in part, “Continued U.S. leadership in biotechnology development is not guaranteed. Researchers, inventors, and investors agree that there are significant policy and investment roadblocks that could hinder biotechnology growth and innovation in the United States. One such roadblock is U.S. Government oversight for biotechnology, which needs to be clarified and streamlined. Another roadblock is a lack of both physical infrastructure and the workforce required to operate it. An investment in both human capital and physical infrastructure is critical to continued U.S. leadership in biotechnology. This investment need not come just from government but should draw on both public and private sources of funding, as did the CHIPS and Science Act.”
“After Grilling Fauci on COVID Origins, House Republicans Want to Consider New Rules for Foreign Research”
Sarah Owermohle details the outcome of a recent closed-door briefing during which House GOP members grilled former NIAID Director, Anthony Facui, in this article for STAT News. She explains, “That included lengthy interrogations about federal oversight of foreign labs that received U.S. funding, including the Wuhan Institute of Virology, a Chinese research establishment that has been central to unproven theories that the virus was leaked from a lab rather than spread to humans from animal contact. In April 2020, President Trump ordered the National Institutes of Health to terminate a coronavirus-focused research project by EcoHealth Alliance based at the Wuhan lab…GOP lawmakers told STAT they were unsatisfied by Fauci’s answers on those grants and the agency’s requirements for funding infectious disease research abroad.”
She continues later in the piece, writing “Those potential improvements include a “better vetting process” for grantees working with labs outside the U.S., and ways to hold them to higher biosafety requirements like properly ventilated spaces, Griffith said.”
“Global Health Security and Diplomacy in 2024: Lead, Leverage, and Elevate”
Hillary H. Carter and Thomas J. Bollyky recently published this piece in Think Global Health discussing key ways to improve human and environmental health in 2024. They focus on turning the themes of lead, leverage, and elevate from “buzzwords to action,” discussing leading through partnerships, leveraging investments for global health security, and elevating health security as a foreign policy priority. They write in their conclusion, “If cooperation, coordination, collaboration, and communication are the cornerstones of efforts to strengthen global health security in 2024 and beyond, diplomacy can harness humanity’s collective potential to meet the health security challenges of the days and years ahead.”
“Interpreting the Biological Weapons Convention – What Are “Necessary Measures” Under Article IV of the Convention?”
Sally Longworth recently published this report with the Swedish Defence Research Agency. She explains in her summary, “Article IV of the Biological Weapons Convention 1972 (BWC) requires States Parties to implement national implementation measures to prohibit and prevent the development, production, stockpiling, retention, acquisition, transfer, and use of biological agents, toxins and weapons in violation of the Convention. No definition of “national implementation measures” is included in the treaty, but there has been over 50 years of State practice in implementing this obligation, which can provide guidance on how States Parties interpret the obligations under Article IV. The Final Declarations agreed by consensus by States Parties at the Convention Review Conferences held every five years are particularly useful tools in understanding what measures are required and what, if any, development there has been in interpreting Article IV. Using legal methods to interpret international treaties, this memo first analyses the obligations set out in Article IV and then considers the interpretative value of the Final Declarations in relation to the BWC. It goes on to highlight a number of measures identified by the States Parties considered necessary in the implementation of the obligations contained in Article IV and important developments in what must be covered.”
“STCE Implementation Guide 2023 Version”
From the World Customs Organization: “The Strategic Trade Control Enforcement Implementation Guide has been the backbone of the STCE programme since its inception in 2016. The latest update of the Guide is currently available in English, and it contains, among other things, updated HS codes of strategic commodities, as well as new Annexes on Post Control Audit and Investigations. Other language versions will follow in 2024.”

NEW: Advancing Threat Agnostic Biodefense Webinar Series
From PNNL: “Join us as we welcome Dr. Betsy Pugel, Planetary Protection Group Lead at the NASA Goddard Space Flight Center. Her talk, titled “Planetary Protection and the Interaction Potential for Fragments Returned to the Earth’s Biosphere from Asteroid or Cometary Material” will be Tuesday, January 16, at noon PT.”
“Is there evidence to ponder the re-evaluation of threats from Unrestricted Earth Returns? When NASA returns samples from planetary bodies, those extraterrestrial samples can be subject to containment if the environment may support life as we currently know it. The temperature, presence of water, and levels of ionizing and non-ionizing radiation present may support that life and so, interaction potential between those extraterrestrial samples and Earth are reduced by taking containment or sterilization measures, known as Restricted Earth Return.”
Register here.
“When Medicine Stops Saving Us: The Antimicrobial Resistance Crisis”
“Interim Dean Abel Valenzuela and the UCLA Division of Social Sciences present an exclusive screening of a new documentary from the team behind the award winning NETFLIX documentary, RESISTANCE. This genre-bending short film, HOLOBIOME, features the harrowing story of UCLA graduate Bradley Burnam’s personal encounter with a deadly superbug. Through a variety of creative elements, HOLOBIOME examines the need for innovation in AMR and questions the overall human relationship with infectious disease and the microbial world. The screening will be followed by an interdisciplinary panel discussing the looming AMR crisis through the lenses of sociology, public policy, industry, and public health.”
This event will be moderated by Biodefense PhD Program alumna Jomana Musmar. It will take place on January 22, at 5 pm PST. Learn more and register here.
AI Executive Order Report Card Reviewing the First 90 Days
“On October 30, 2023, the Biden Administration issued a call to action outlining a host of requirements and deliverables for U.S. government agencies on artificial intelligence. The executive order touched on a range of AI-relevant issues, including testing and evaluation of new AI systems, developing a healthy and capable U.S. AI workforce, and ensuring U.S. competitiveness in the years to come.”
“Join CSET researchers on January 31, 2024, for a discussion of what the U.S. Government has accomplished so far, what have we learned, and what’s left to do to complete the EO’s ambitious goals.”
This online event will begin at 12 pm EST. Learn more and register here.
International Conference, CBRNE Research & Innovation
“The last 40 years have demonstrated that both military and civilian populations could be exposed to highly hazardous CBRNE agents following conflicts, natural outbreaks and disasters, industrial incidents or terrorist attacks.”
“Worldwide, researchers, responders and industrial capacities have been commited to provide adapted response to these challenges.”
“Building on the success of the first 5 International Conferences « CBRNE Research and Innovation » which took place in Antibes (2015), Lyon (2017), Nantes (2019), on line (2021) and Lille (2022), we want to give you a new opportunity to build up or strengthen collaborative networks in Strabourg (March 19th – 21rst 2024).”
“The CBRNE R&I Conference is specifically devoted to scientific updates, responders’ feedbacks and expression of needs. It also includes workshops and demonstrations of innovative materials, technologies and procedures, according to the following themes: DETECTION – IDENTIFICATION, PROTECTION – DECONTAMINATION, MEDICAL COUNTERMEASURES, RISKS & CRISIS MANAGEMENT.”
“Looking forward to your proposals for communication and to welcoming you at Strasbourg in March 2024!”
Learn more here.
Registration for GHS 2024 Now Open
Registration is now open for the Global Health Security 2024 conference in Sydney, Australia. This iteration will take place 18-21 June, 2024. The call for abstracts is also still open. “The mission of the Global Health Security conference is to provide a forum where leaders, researchers, policy-makers, and representatives from government, international organisations, civil society, and private industry from around the world can engage with each other, review the latest research and policy innovations, and agree solutions for making the world safer and healthier. To that end, our mission is to help foster a genuinely multidisciplinary community of practice that is committed to working collaboratively to enhance global health security and eliminate disease, irrespective of its origin or source.”





 WHO Leadership Prioritization
WHO Leadership Prioritization Summer Workshop – Don’t Miss Out!
Summer Workshop – Don’t Miss Out! Scientists Utilize Old School Approach Against Resistant Bacteria
Scientists Utilize Old School Approach Against Resistant Bacteria

 Ebola Burial Teams
Ebola Burial Teams 



 This past Saturday (Earth Day), cities around the world saw hoards of scientists and supporters of research marching to both celebrate science, but also push for the preservation of funded and publicly communicated research. “The March for Science is a celebration of science. It’s not only about scientists and politicians; it is about the very real role that science plays in each of our lives and the need to respect and encourage research that gives us insight into the world. Nevertheless, the march has generated a great deal of conversation around whether or not scientists should involve themselves in politics. In the face of an alarming trend toward discrediting scientific consensus and restricting scientific discovery, we might ask instead: can we afford not to speak out in its defense?” Cities like Chicago saw 40,000 participating in the march, armed with lab coats, pink knit brain hats, and
This past Saturday (Earth Day), cities around the world saw hoards of scientists and supporters of research marching to both celebrate science, but also push for the preservation of funded and publicly communicated research. “The March for Science is a celebration of science. It’s not only about scientists and politicians; it is about the very real role that science plays in each of our lives and the need to respect and encourage research that gives us insight into the world. Nevertheless, the march has generated a great deal of conversation around whether or not scientists should involve themselves in politics. In the face of an alarming trend toward discrediting scientific consensus and restricting scientific discovery, we might ask instead: can we afford not to speak out in its defense?” Cities like Chicago saw 40,000 participating in the march, armed with lab coats, pink knit brain hats, and 
 Welcome to the start of the weekend and
Welcome to the start of the weekend and Unseen Enemy Documentary
Unseen Enemy Documentary  CARB-X Mission
CARB-X Mission




